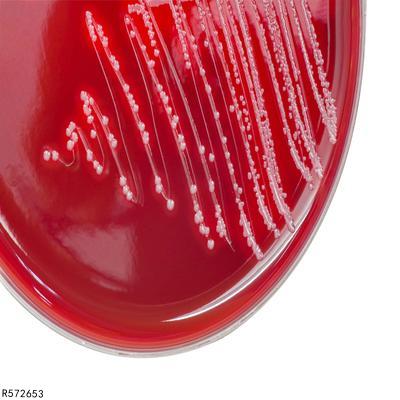

结核菌在医学上还被称为结核分枝杆菌,这种细菌主要是结核病的病原体,该细菌能够入侵全身的各个器官,对患者的身体有着很大的危害,特别是非常容易感染肺部。因此,患者若想彻底避免这种细菌,就应该从根本解决问题,就是了解到底如何快速培养的结核杆菌,只有了解了培养方法才是最为重要的事情,那么到底如何培养呢?那就一起来了解了解吧!
1.固体培养法
培养结核杆菌有很多种方法,而固体培养法就是其中一种,也是比较重要的一种方法。该种方法主要是以鸡蛋为基础,主要是使用高温凝固形成固体培养基两个,在正常情况下大约2~3周就可以看见细菌生了。
2.液体培养法
结核杆菌的培养除了固体陪养法之外,还可以选择液体培养法。培养者可以将营养丰富的细菌放置于装有液体的器皿之中,使细菌与营养物质得到比较充分的接触。这种方式非常有利于结核分支杆菌迅速生长,一般在大约1~2周就可看见细菌的生长,而且这种情况下培养出来的结核分枝杆菌培养是比较重要的,也是鉴别结核菌的一种特别重要的诊断方式之一。
3.根据情况进行培养
培养结核菌也必须要分情况来进行确定的,而结核菌培养阳性率远高于痰液抗酸杆菌涂片。因此当患者被诊断出痰抗酸杆菌涂片多次阴性的疑似患者,那就非常有必要在医生的指导下进行结核菌培养,而且在确定好的情况下来进行培养,可以更加准确快速的培养出结核菌。
4.药敏感性实验
培养者还可以对结核菌进行药敏感性试验,这种培养方法可以让培养人根据实验的结果选择最佳敏感的抗结核药物。并且只有通过这种方法才可以使结核菌的试验取得最佳的治疗效果。
上面主要讲述了几种快速培养结核菌的几种方法,希望可以帮助到培养者,只有按照科学的方法进行培养,才能快速准确的培养出结核菌。当然,除了这些方法之外还有更多的好的方法可以使细菌快速的培养出结核菌,那就希望培养者自己去挖掘出来吧!